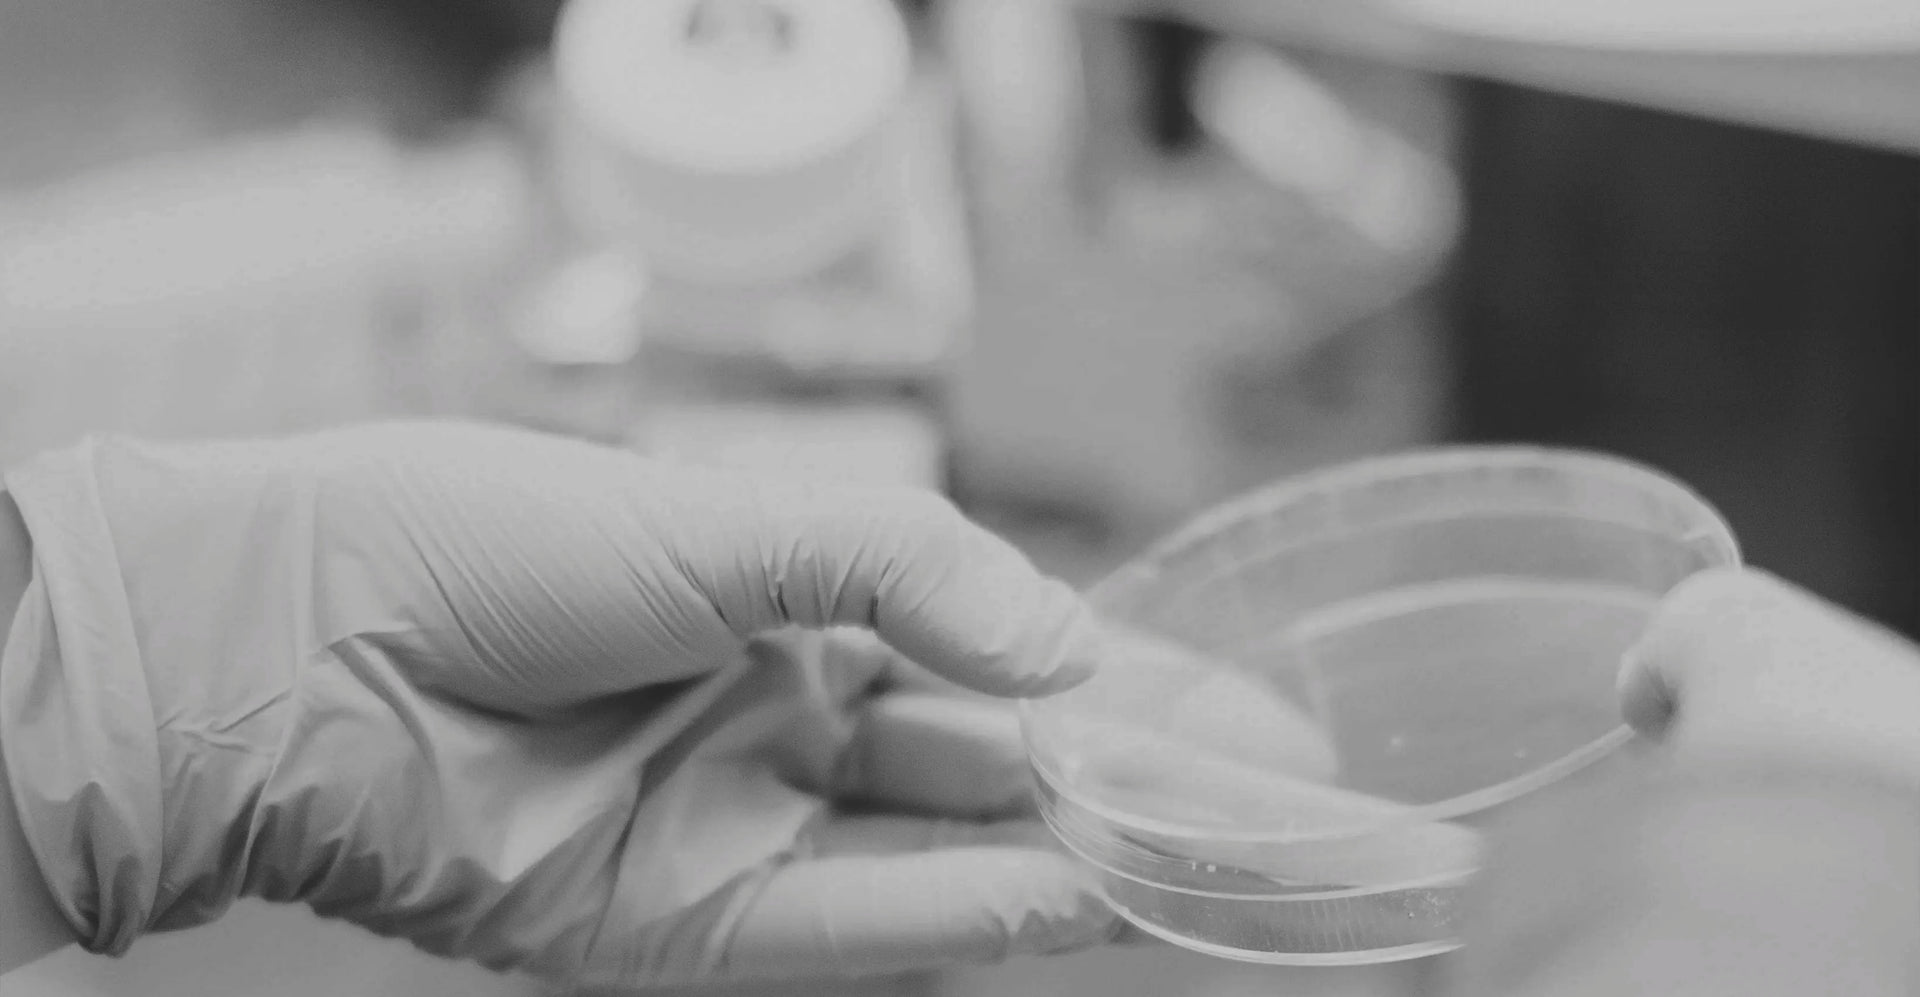

Med Care
3 x Cream
- Normaler Preis
- €119,70
- Verkaufspreis
- €94,90
- Normaler Preis
- €94,90
💧 Schenkt Ihrer Haut die benötigte Feuchtigkeit
✅ Beruhigt die Haut
✨ Zieht schnell ein, ohne zu fetten
Beschreibung
Beschreibung
Highlights
Highlights
Inhaltsstoffe
Inhaltsstoffe
Anwendung
Anwendung
Zufriedenheits-Garantie
Zufriedenheits-Garantie
Wir sind von unseren Produkten überzeugt und wollen, dass du dich mit unseren Lösungen wohlfühlst. Deshalb möchten wir dir mit unserer Zufriedenheitsgarantie entgegenkommen. Solltest du mit unseren Produkten nicht zufrieden sein, kannst du innerhalb von 90 Tagen nach dem Erhalt der Ware eine Erstattung beantragen. Wir erstatten dir dann den vollen Kaufpreis zurück.





Die Allround-Pflege für jeden Tag

Hautpflege, die wirkt
Nur die hochwertigsten Inhaltsstoffe
Wir nutzen ausschließlich Inhaltsstoffe, deren Wirksamkeit wissenschaftlich bestätigt wurde, wie zum Beispiel ...
Panthenol
Jojbaöl
Aloe Vera Saft
NEEMAVERA
Ectoin
Das macht natüür besonders


Simpel und effektiv
Wir sind der Überzeugung, dass eine Pflegeroutine nicht kompliziert sein darf, und eine Formulierung nicht komplex. Hautpflege muss simpel und effektiv sein! Sie sollte sich immer dem eigenen Lebensstil anpassen und nicht umgekehrt.

Entzündungshemmend und antioxidativ
Dermatest hat in einer in-vitro-Studie die herausragenden Eigenschaften von NEEMAVERA untersucht: Die Studie bestätigt seine Wirkung nicht nur als besonders hautverträglich, sondern auch als entzündungshemmend und antioxidativ.


Unser bestes Neem
Als Familienunternehmen verfügen wir über die größte Neem-Plantage der Welt. Dort kontrollieren wir die gesamte Wertschöpfungskette. Von der Anzucht der Setzlinge von Hand bis zu Ernte und Verarbeitung unserer Neem-Blätter.


NEEMAVERA – unser größter Schatz
In einem speziell entwickelten Verfahren stellen wir in Deutschland unser eigenes Neem-Extrakt NEEMAVERA her. Dieses bildet die Basis für unsere Hautpflegeprodukte – allesamt wissenschaftlich entwickelt und dermatologisch getestet.
Häufig gestellte Fragen